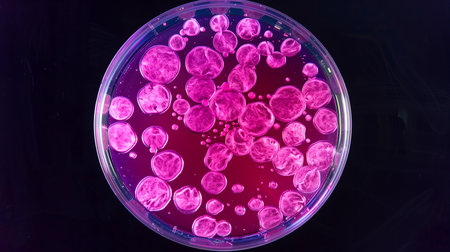
Colored stem cell cultures showcase potential in regenerative medicine for transformative therapiesの素材

素材 - Colored stem cell cultures showcase potential in regenerative medicine for transformative therapies
作品情報
Colored stem cell cultures showcase potential in regenerative medicine for transformative therapies
- ID:248525597
- 作品種別:
- 作者名:milkos
キーワード
- advancement
- ai
- analysis
- applications
- biological
- biology
- biotechnology
- cell
- cellular
- culture
- development
- discovery
- experimentation
- experiments
- exploration
- future
- generated
- growth
- healing
- health
- healthcare
- innovation
- insights
- laboratory
- life
- liquid
- medical
- medicine
- microscopic
- organisms
- pluripotent
- regeneration
- regenerative
- renewal
- research
- safe
- sciences
- scientists
- solutions
- stem
- structures
- studies
- techniques
- technology
- therapy
- tissue
- treatments
- vital
類似作品
This striking i...
Vivid colors de...
Bacterial colon...
Vivid Connectiv...
microbial cultu...
cross-section o...
acrylic paints ...
Microscopic Org...
Microbiology.
Colorful variet...
Conceptual imag...
Abstract bright...
Microscopic Vie...
Close-up detail...
Laboratory tech...
A vibrant molec...
Microscopic Org...
Abstract illust...
Macro close up ...
A colorful wate...
nanoparticle so...
Microscopic Vie...
Abstract colorf...
Colored molecul...
Laboratory for ...
Laboratory petr...
3d illustration...
Vibrant and col...
microbial cultu...
A vibrant close...
Blue bacteria a...
3d render of vi...
Petri dish with...
Close-up of a p...
Cells and struc...
A vibrant, clos...
hand of a techn...
Bacteria Peptoc...
Discover the fa...
A cluster of va...
Microscopic 3D ...
Conceptual imag...
Macro shot of c...
petri dish with...
Laboratory tech...
Abstract colorf...
A vibrant, glow...
Close up of vir...